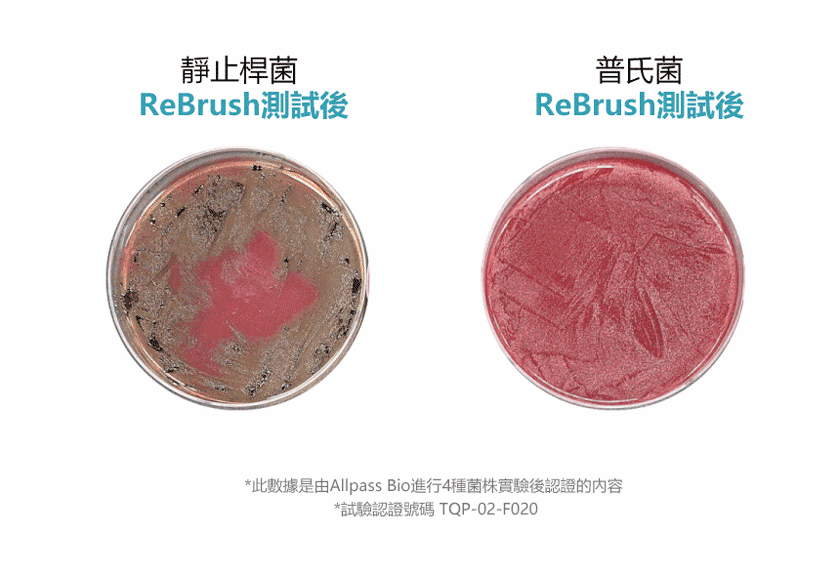

{{ 'fb_in_app_browser_popup.desc' | translate }} {{ 'fb_in_app_browser_popup.copy_link' | translate }}
{{ 'in_app_browser_popup.desc' | translate }}
AKIII Classic買兩對九折!
{{ childProduct.title_translations | translateModel }}
{{ getChildVariationShorthand(childProduct.child_variation) }}
{{ getSelectedItemDetail(selectedChildProduct, item).childProductName }} x {{ selectedChildProduct.quantity || 1 }}
{{ getSelectedItemDetail(selectedChildProduct, item).childVariationName }}
✔ 鋁製瓶身保持新鮮
✔ 無酒精、無色素、高保濕
✔ 含益生菌,維持口腔健康
✔ 幫助保持口氣清新,有效去除口中異味
✔ 約可使用100次
(配合正確刷牙習慣)
全店,滿$800免運費 (不含偏遠地區/特殊住宅附加費)
全店,澳門滿$900免運費
商品存貨不足,未能加入購物車
您所填寫的商品數量超過庫存
{{'products.quick_cart.out_of_number_hint'| translate}}
{{'product.preorder_limit.hint'| translate}}
每筆訂單限購 -1 件
{{'products.quick_cart.quantity_of_stock_hint'| translate : {message: quantityOfStock} }}

成分表:
Cetylpyridinium Chloride, Glycerin
Concentrated, Citric Acid, Sodium Bicarbonate, Zinc Oxide, Xylitol,
Enzymatically Treated Stevia, L-Menthol, Quince Flavor, Lemon Mint Flavor, Mint
Flavor, Clove Oil, Propolis Extract, Royal Jelly Extract, Lemon Extract,
Rosemary Extract, Bifidus Extract, Aloe Vera Gel, Potassium Sorbate, Sodium
Ascorbate, Tocopheryl Acetate, PEG-60 Hydrogenated Castor Oil, Distilled Water